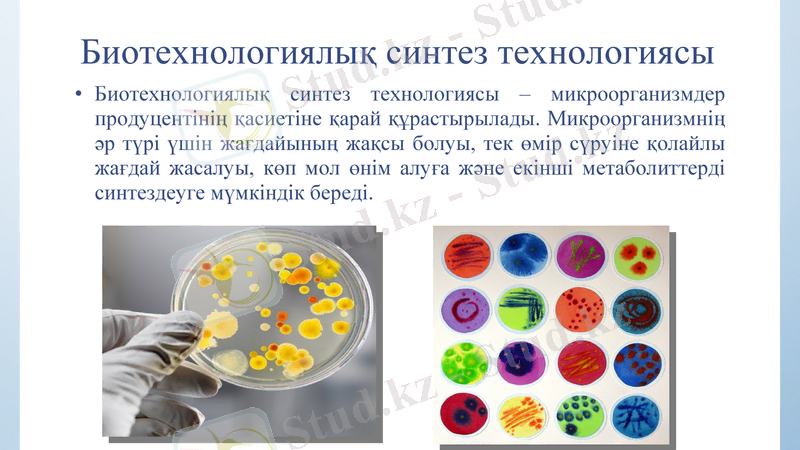
Slide 2
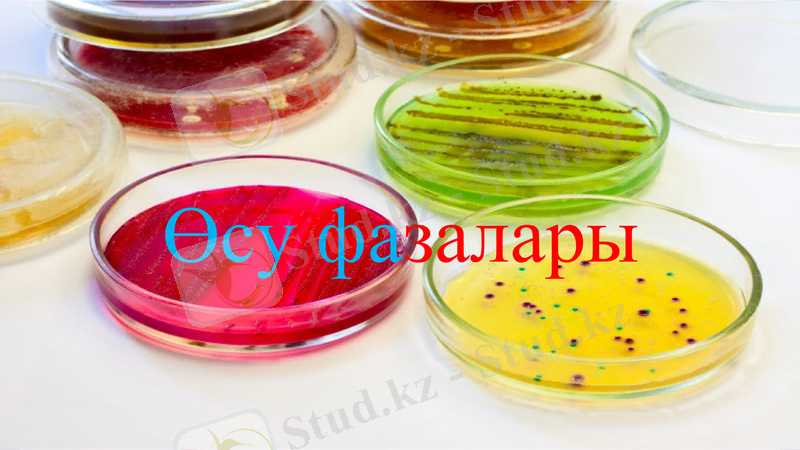
Slide 5

Микроорганизмдерді культивтеу әдістері және өсу фазалары



Микроорганизмдерді культивирлеу әдістері
Биотехнологиялық синтез технологиясы
Биотехнологиялық синтез технологиясы - микроорганизмдер продуцентінің қасиетіне қарай құрастырылады. Микроорганизмнің әр түрі үшін жағдайының жақсы болуы, тек өмір сүруіне қолайлы жағдай жасалуы, көп мол өнім алуға және екінші метаболиттерді синтездеуге мүмкіндік береді.

Микроорганизмдерді культивирлеу әдістері
Микроорганизмдерді кезеңді түрде культивирлеу.
Егіс материалын алу барысында көбінесе культивилеудің кезеңді әдісі қолданылады. Кезеңдік культивирлеу микробты биосинтезде алдымен кезеңді культураның өсу динамикасын зерттеуден басталады. Периодты культураның дамуы үшін қоректік ортаға микроорганизмдер материалы егіледі.

Өсу фазалары графикалық түрде көрсетілуі мүмкін. Жассушаның санын шыны ыдыстқа егіс материалын еккен кезден бастап анықтаса, әрбір уақыт мерзімі белгіленіп, абцисса осіне жіберіледі, жасушаның белгілі санына сәйкестендіріліп ординат осіне жіберіледі. Бұл қисықты микроорганизмдердің өсу қисығы деп атайды және бірнеше фазаларға немесе периодтарға бөледі.
Өсу фазалары

I-фаза
Лаг-фаза немесе бейімделу фазасы деп аталады. Мұнда жаңадан жасалған қоректік ортаға жіберілген микроорганизмдер көбеймейді, қайта бейімделеді. Бұл фаза 1-2 сағатқа созылады. Фаза аяқталғаннан кейін жасуша көбейе бастайды. Қоректік ортаны пайдалану қуатты түрде жүреді.
Микроорганизмдер көбейгенге дейін қоректік орта инокуляторға енгізіліп отырады. Бұл кезеңде культура жаңа ортаға бейімделеді, бұл фазаның ұзақтығы микроорганизмдердің физиологиялық ерекшелігіне және культивирлеу жағдайына, байланысты егіс материалына және өндірістік орта құрамына байланысты болады. Мұндай айырмашылық аз болған сайын және егілетін микроорганизмдердің мөлшері неғұрлым көп болса, онда 1 фазаның өсуі соғұрлым қысқа болады.

ІІ фаза
Өсу жылдамдығының фазасы немесе ауыспалы деп аталады. Бұл жасушаның бөліне бастауы болып сипатталады. Бұл сатыда жасушадағы нуклеин қышқылының (ДНҚ, РНҚ) ақуыздың құрамы жоғарылайды, жасушаның көлемі ұлғаяды. Жасуша беті белгілі қатынасы аралық жетістігінің арқасында және оның көлемі жасушаның бөлінуімен жүргізіледі, нәтижесінде культураның өсу жылдамдығы мен популяция саны ұлғая бастайды. Әдетте бұл фазаның жалғасы жоқ.

ІІІ фаза
Жасуша санының анағұрлым активті өсу фазасы. Даму фазасы көбейюдін ең активті фазасы. Онда микроорганизмдер қарқынды дамиды, өсу шапшандығы да арта түседі. Бұл екі сағаттай уақытқа созылады. Кейбір жасушалар тіршілігі тежеле бастайды. Ол экспоненциалды немесе логарифмдік фазаның өсуі деп аталады. Бұл фазада жасуша белгіленген өсу жағдайына толығымен бейімделгеннен кейін басталады, культураның өсуі қоректік зат түспесе де, азықтық зат алмасуы мол болмаса да шектелмейді. Өсу жылдамдығының максимальдығы бекітіледі.
Микроорганизмдердің қарқынды өсуінің және қоректік микроорганизмдердің көбеюінің нәтижесінде дәл осы қарқындылық пен қоректік заттар жұмсалады да, өмір сүруші микроорганизмдердің өнімдері жиналады. Сонымен қатар бос кеңістік шектеледі, жасушалар өсу барысында бір-біріне бөгет жасайды, жасушаларға қоректік заттардың келуі және метаболиттердің бөлінуі нашарлайды. Өсу жылдамдығы төмендейді, жасушалардың бөлінуі қысқарып, содан соң өсудің келесі фазасы басталады.

IV фаза
Баяу өсу фазасы немесе өсу жылдамдығының төмендеуі. Бұл фазаның, экспоненциалды фазаға қарағанда жасушалар бітекті болмайды, себебі қолайсыз факторлардың әсерінен қоректік зат концентрациясы төмендейді, зат алмасуда өнімнің жиналуы өседі. Мұның барлығы культураның өсу процесінің баяулануына және тоқтап қалуына әкеліп соқтырады, сонымен қатар олардың жойылуы және жасушаларда лизес бөлігінің тууы мүмкін.

V фаза
Стационарлы фаза деп аталады. Стационарлы фазада жаңадан пайда болған жасушалар мен қырылған жасушалар саны теңеледі. Сондықтан тірі жасушалар саны біраз уақыт тұрақты болып қала береді. Көбею кезінде түзілген өнімдер микробтар тіршілігіне нұқсан келтіре бастайды. Бұл фаза бірнеше сағаттан бірнеше күнге дейін созылады. Стационарлы фазада биомасса культурасының өсуі тоқтайды.

VI фаза
Қырылу фазасы немесе жойылу фазасы. Қырылу фазасында пайда болған жасушалар санынан өлген жасушалар саны басым болады. Қоректік ортаның физикалық-химиялық қасиеті мүлде өзгеріп, микроорганизмдер тіршілігіне зиянды жағдайға көшеді. Жасушалардың қырылу жылдамдығы арта түседі. Ол өлген жасушалардың саны қайта пайда болған жасушалар санынан көп болған кезден бастап басталады. Бұл фазада жасушалардың өмір сүру жағдайлары қолайсыз, ал жасушапардың артық заттарының қоры таусылады.

Назарларыңызға рахмет!!!
- Іс жүргізу
- Автоматтандыру, Техника
- Алғашқы әскери дайындық
- Астрономия
- Ауыл шаруашылығы
- Банк ісі
- Бизнесті бағалау
- Биология
- Бухгалтерлік іс
- Валеология
- Ветеринария
- География
- Геология, Геофизика, Геодезия
- Дін
- Ет, сүт, шарап өнімдері
- Жалпы тарих
- Жер кадастрі, Жылжымайтын мүлік
- Журналистика
- Информатика
- Кеден ісі
- Маркетинг
- Математика, Геометрия
- Медицина
- Мемлекеттік басқару
- Менеджмент
- Мұнай, Газ
- Мұрағат ісі
- Мәдениеттану
- ОБЖ (Основы безопасности жизнедеятельности)
- Педагогика
- Полиграфия
- Психология
- Салық
- Саясаттану
- Сақтандыру
- Сертификаттау, стандарттау
- Социология, Демография
- Спорт
- Статистика
- Тілтану, Филология
- Тарихи тұлғалар
- Тау-кен ісі
- Транспорт
- Туризм
- Физика
- Философия
- Халықаралық қатынастар
- Химия
- Экология, Қоршаған ортаны қорғау
- Экономика
- Экономикалық география
- Электротехника
- Қазақстан тарихы
- Қаржы
- Құрылыс
- Құқық, Криминалистика
- Әдебиет
- Өнер, музыка
- Өнеркәсіп, Өндіріс
Қазақ тілінде жазылған рефераттар, курстық жұмыстар, дипломдық жұмыстар бойынша біздің қор #1 болып табылады.



Ақпарат
Қосымша
Email: info@stud.kz